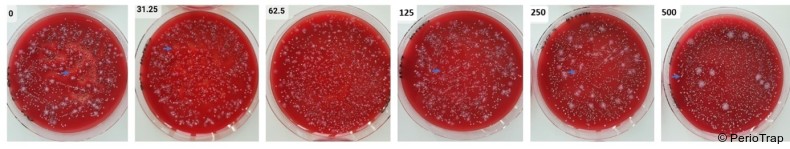

Parodontologie 01.12.2025
Pathoblocker-basierte Virulenzmodulation von Porphyromonas gingivalis
Die klassische Parodontitistherapie setzt auf mechanische Plaquekontrolle, häufig ergänzt durch antimikrobielle Wirkstoffe. Doch dieser Ansatz hat seine Grenzen: Antibiotika wie das Van-Winkelhoff-Protokoll, Amoxicillin plus Metronidazol, treiben Resistenzentwicklungen voran und verursachen systemische Nebenwirkungen. Antiseptika wie Chlorhexidin führen bei längerer Anwendung zur wiederkehrenden unspezifischen Abtötung aller Bakterien und so zu einer schrittweisen Veränderung innerhalb des Mikrobioms hin zu mehr pathogenen Keimen3,4. Daneben kann die Daueranwendung häufig zu unerwünschten Verfärbungen und Geschmacksbeeinträchtigungen führen5.
Resistenzen verringern, Mikrobiom schonen
Als vielversprechende Alternativen rücken, zunehmend sogenannte Pathoblocker als spezifische Form der Next Generation Antimicrobials ins Rampenlicht6. Diese Substanzen verfolgen eine grundlegend andere Strategie: Statt Bakterien abzutöten, nehmen sie ihnen gezielt die Pathogenität, indem sie spezifische Virulenzfaktoren hemmen. Dadurch entsteht ein deutlich geringerer Selektionsdruck für die Ausbildung von Resistenzen, und die kommensale Mikrobiota bleibt weitgehend verschont. Im Zentrum dieser innovativen Strategie bei parodontalen Beschwerden steht die bakterielle Typ II Glutaminylcyclase (PgQC) von P. gingivalis – ein Enzym, das die Zyklisierung N-terminaler Glutaminreste zu Pyroglutamat katalysiert. Diese posttranslationale Modifikation von Eiweißstoffen ist für die Funktionalität zahlreicher Virulenzfaktoren unverzichtbar7.
Neben P. gingivalis besitzen noch zwei weitere wichtige Pathogene eine solche Typ II QC: Tannerella forsythia, wie P. gingivalis im roten Komplex verortet, und Prevotella intermedia aus dem orangenen Komplex8,9. Zwei aktuelle wissenschaftliche Arbeiten von Taudte und Kollegen sowie von Eick und Mitarbeitern untersuchen nun systematisch, wie effektiv ein neuartiger PgQC-Inhibitor sowohl in planktonischen Bakterienkulturen als auch in komplexen Mehrspezies-Biofilmen wirkt. Beide wissenschaftlichen Artikel haben noch nicht abschließend den Peer-Review Prozess durchlaufen, sind jedoch eingereicht, teilweise akzeptiert und liegen bereits als PrePrint-Versionen vor10,11.
Die Charakterisierung von S-0636
Taudte und ihr Team nahmen sich den neuartigen reversiblen Inhibitor S-0636 vor. Die Substanz wurde umfassend geprüft: auf die Hemmaktivität gegenüber dem Enzym, eine Virulenzfaktor-Modulation, ihren Einfluss auf kommensale Bakterien, ihr Potential zur Resistenzentwicklung und ihre Zytotoxizität auf wichtige humane Zelltypen. Um die inhibitorische Potenz zu bestimmen, inkubierten die Forschenden isolierte rekombinante PgQC mit dem fluorogenen Substrat H-Gln-AMC und ermittelten so die Hemmkonstante (Ki). Parallel dazu untersuchten sie, wie sich S-0636 auf die intrazelluläre PgQC-Aktivität auswirkt, indem sie verschiedene P. gingivalis-Stämme (ATCC 33277 und W83) über 42 Stunden mit steigenden Inhibitorkonzentrationen inkubierten. Besonders interessant war die Frage, ob und wie stark S-0636 die Virulenzfaktoren von P. gingivalis beeinflusst. Die Rgp- Gingipain-Aktivität wurde mit dem chromogenen Substrat L-BApNA quantifiziert, die Hämagglutinationsfähigkeit durch Inkubation bakterieller Suspensionen mit defibriniertem Schafblut ermittelt.
Ein besonders aussagekräftiger Test war das Infektionsmodell mit humanen gingivalen Keratinozyten (hTERT-TIGK): Hier untersuchten die Forschenden die Invasivität von S-0636 behandelten P. gingivalis Zellen. Um die Selektivität zu prüfen, testeten sie S-0636 an zehn kommensalen oralen Bakterienspezies, darunter Actinomyces oris, Streptococcus sanguinis und Veillonella parvula. Das Resistenzentwicklungspotential wurde durch 50 serielle Passagen auf S-0636-haltigem Agar untersucht, und eine potenzielle Zytotoxizität ermittelte man mittels WST-8-Assay an vier verschiedenen humanen Zelllinien.
Gezielte Virulenzblockade statt Abtötung
Die Ergebnisse waren vielversprechend: S-0636 erwies sich als hochpotenter PgQC-Inhibitor mit einem Ki-Wert von nur 0,014 µM am isolierten Enzym, deutlich aktiver als früher getestete Verbindungen. In planktonischen P. gingivalis-Kulturen halbierte bereits eine Konzentration von 8 µM die intrazelluläre PgQC-Aktivität. Das zeigt, dass die Substanz effizient durch die bakterielle Außenmembran ins Periplasma gelangt. Das Entscheidende aber ist: Selbst bei sehr hohen Konzentrationen tötet S-0636 die Bakterien nicht ab (Abb. 1), ganz im Gegensatz zu Minocyclin, das bereits bei einer 8000-fach geringeren Konzentration bakterizid wirkt. Hier wird der fundamentale Unterschied zwischen klassischen Antibiotika und Pathoblockern sichtbar.
Die Virulenzfaktor-Analysen bestätigten den Ansatz: Die Rgp-Gingipain-Aktivität sank dosisabhängig parallel zur PgQC- Hemmung. Auch die Hämagglutinationsfähigkeit, die Fähigkeit des Bakteriums an roten Blutzellen zu binden, nahm konzentrationsabhängig ab, und bei hohen Inhibitorkonzentrationen verloren die Bakterien praktisch diese Fähigkeit. Am eindrucksvollsten war jedoch die Reduktion der Invasivität: Bei 62,5 µM verringerte sich die Infektion gingivaler Keratinozyten um 76 Prozent bei 500 µM sogar um über 90 Prozent (Abb. 2). Die Selektivitätstests zeigten, dass zehn getestete kommensale Bakterienspezies bei Konzentrationen bis 250 µM nicht im Wachstum beeinträchtigt wurden, nur Veillonella parvula reagierte bei sehr hohen Dosen moderat empfindlich, vermutlich durch unspezifische toxische Effekte. Nach 50 Passagen auf S-0636-haltigem Medium zeigten die P. gingivalis-Stämme keine veränderten Gingipain-Aktivitätsprofile, was gegen eine Resistenzentwicklung bei diesen Konzentrationen spricht. Die Zytotoxizitätstests ergaben in der höchsten getesteten Konzentration eine Viabilität von über 80 Prozent für Keratinozyten, Nieren- und Leberzellen, während Fibroblasten mit etwa 60 Prozent Viabilität etwas empfindlicher reagierten.
Von der Petrischale zum Biofilm
Eick und ihr Team gingen den nächsten logischen Schritt und untersuchten, wie S-0636 in klinisch relevanteren Mehrspezies-Biofilmen auswirkt. Sie etablierten zwei verschiedene Biofilm-Systeme: einen relativ einfachen Vier-Spezies-Biofilm aus Streptococcus gordonii, Actinomyces naeslundii, Fusobacterium nucleatum und Tannerella forsythia sowie einen komplexeren Zwölf-Spezies-Biofilm, der zusätzlich P. gingivalis, Prevotella intermedia, Campylobacter rectus, Capnocytophaga gingivalis, Eikenella corrodens, Filifactor alocis, Parvimonas micra und Treponema denticola enthielt. Die Biofilme wurden auf Protein-beschichteten 96-Well-Platten kultiviert, und nach sechsstündiger initialer Biofilmbildung gaben die Forschenden S-0636 in verschiedenen Konzentrationen hinzu, gefolgt von weiteren 18 Stunden Inkubation.
Das Analyseprogramm war umfassend: Gesamtbakterienanzahl, speziesspezifische Bakterienzahlen per qPCR, Biofilmmasse durch Kristallviolett-Färbung, metabolische Aktivität mittels Resazurin-Assay und natürlich die Rgp-Gingipain-Aktivität. Besonders spannend war die immunmodulatorische Komponente: Die vorbehandelten Biofilme wurden mit der monozytären Zelllinie MONO-MAC-6 co-inkubiert, und die Freisetzung von IL-1β (pro-inflammatorisch) und IL-10 (anti-inflammatorisch) per ELISA gemessen. Mittels Fluoreszenz-in-situ-Hybridisierung (FISH) und konfokaler Laserscanningmikroskopie visualisierten sie außerdem die räumliche Verteilung von P. gingivalis und T. forsythia im Biofilm.
Die Ergebnisse zeigten interessante Unterschiede zwischen den beiden Biofilm-Systemen: Der Vier-Spezies-Biofilm (ohne P. gingivalis) reagierte kaum auf S-0636 – weder Bakterienzahl noch Biofilmmasse oder metabolische Aktivität änderten sich signifikant. Das könnte daran liegen, dass der Inhibitor gegenüber der QC von T. forsythia weniger potent ist als gegenüber der von P. gingivalis. Im Zwölf-Spezies-Biofilm hingegen wurden dosisabhängige Effekte sichtbar, wobei die Gesamtbakterienanzahl sowie die Zellzahlen von P. gingivalis und T. forsythia unbeeinflusst blieben – ein weiterer Beleg für die nicht-bakterizide Wirkweise (Abb. 3). Interessanterweise sanken die P. intermedia-Zahlen konzentrationsabhängig, möglicherweise weil die Koaggregation mit P. gingivalis gestört war.
S-0636 stört, hemmt und moduliert
Die Biofilmmasse reduzierte sich bei hohen Konzentrationen zum Kontrollwert um etwa ein Viertel (jeweils hochsignifikant). Auch die metabolische Gesamtaktivität nahm signifikant ab. Diese Reduktionen deuten darauf hin, dass S-0636 die synergistischen Interaktionen bei der Biofilmbildung stört.
Die Rgp-Gingipain-Aktivität verringerte sich ebenfalls dosisabhängig signifikant: Phänotypisch war das gut zu erkennen: Die charakteristische Schwarzpigmentierung der P. gingivalis - Kolonien verschwand konzentrationsabhängig (Abb. 4). Offensichtlich interferiert S-0636 in der Häm-Akquisition, in der Gingipaine eine entscheidende Rolle spielen.
Die FISH-Aufnahmen zeigten bei der höchsten Konzentration von S-0636 eine geringere Biofilmdicke, während die räumliche Verteilung der Bakterienspezies erhalten blieb: P. gingivalis primär basal, T. forsythia in den mittleren Schichten in charakteristischen Clustern. Die immunmodulatorischen Analysen brachten ein weiteres wichtiges Ergebnis: Der Zwölf-Spezies-Biofilm ohne Inhibitor induzierte die höchste IL-1β-Freisetzung aus Monozyten, und die Inkubation des Biofilms mit S-0636 reduzierte diese pro-inflammatorische Reaktion konzentrationsabhängig signifikant (Abb. 5). Die IL-10-Spiegel wurden durch Biofilm-Exposition generell verringert, ohne zusätzlichen Inhibitor-Effekt. Das deutet auf eine Verschiebung von einem stark pro-inflammatorischen (M1) zu einem ausgeglicheneren Makrophagen-Phänotyp hin.
Selektive Pathoblockade als Alternative zu Antibiotika
Die beiden Studien demonstrieren eindrucksvoll das Potential von PgQC-Inhibitoren als innovative Pathoblocker sowohl für die Parodontitisvorsorge als auch für spätere therapeutische Optionen. Der zentrale Ansatz beruht auf der reversiblen, kompetitiven Hemmung der periplasmatischen PgQC, wodurch die Pyroglutaminylierung N- terminaler Glutaminreste von Virulenzfaktoren verhindert wird. Das betrifft vermutlich über 70 Prozent aller sekretierten P. gingivalis-Proteine (12), einschließlich der Gingipaine (RgpA, RgpB, Kgp), des Hämagglutinins HagA und diverser Komponenten des Typ-IX- Sekretionssystems. Die fehlende N-terminale Modifikation führt vermutlich zu reduzierter Proteinstabilität, gestörter Sekretion und funktioneller Beeinträchtigung dieser Virulenzfaktoren.
Der entscheidende Vorteil gegenüber konventionellen Ansätzen liegt in der fehlenden bakteriziden Wirkung: S-0636 lässt P. gingivalis am Leben und damit in seiner ökologischen Nische, nimmt ihm aber die krankmachende Wirkung. Das minimiert einerseits den Selektionsdruck für Resistenzentwicklung – experimentell bestätigt durch die fehlende Resistenzinduktion nach 50 Passagen unter den getesteten Bedingungen. Außerdem bleiben kommensale Bakterienspezies unbeeinträchtigt. Damit kann sich innerhalb des oralen Mikrobioms die Dysbiose, verursacht unter anderem durch P. gingivalis, T. forsythia und P. intermedia, gar nicht erst ausbilden bzw. manifestieren, was S-0636 für die Verwendung in oral-care Produkten qualifiziert.
Die Biofilm-Studien belegen hingegen auch eine mögliche klinische Relevanz: In komplexen Zwölf-Spezies-Biofilmen reduziert S-0636 nicht nur direkt die P. gingivalis- Virulenz, sondern beeinträchtigt auch synergistische Interaktionen, die zur Biofilm-Matrix-Synthese beitragen, was letztlich indirekt zu einer verminderten IL-1β- Freisetzung aus Monozyten führt.
Bedeutung für Mundhygiene
Für die Umsetzung in einer späteren Medikamentenentwicklung für die gezielte Parodontitistherapie sind allerdings noch einige Fragen zu klären: Die konzentrationsabhängige Wirkung erfordert ausreichend hohe lokale S-0636-Spiegel im parodontalen Gewebe. In vivo muss die rasche Verdünnung durch Speichel stimuliert oder unstimuliert (287-640 µl/min) und Sulkusfluid (0,5 µl/min) berücksichtigt werden – Slow-release-Formulierungen oder hochkonzentrierte Applikationsformen, die direkt in die Zahntaschen eingebracht werden, könnten hier Lösungen bieten. Die moderate Zytotoxizität gegenüber Fibroblasten muss weiter untersucht werden, dürfte aber bei den therapeutisch relevanten Konzentrationen kein limitierendes Problem darstellen.
Insgesamt bestätigen die Ergebnisse dieser Arbeiten PgQC als valides Target für eine Pathoblocker-basierte Parodontitisvorsorge und spätere therapeutische Ansätze. S-0636 zeigt ein vielversprechendes Profil hinsichtlich Potenz, Selektivität, fehlender Resistenzinduktion und Biofilm-Modulation. Als adjuvante Komponente in Mundpflegeprodukten könnte dieser Ansatz die unterstützende Parodontitistherapie grundlegend verändern, indem der sich nach der Reinigung der betreffenden Stellen normalerweise sofort wiederaufbauende Biofilm in einen eubiontischen Bereich moduliert wird, den kommensalen Bakterien bei der Wiederbesiedelung so einen Vorteil verschafft wird. Weiterführende Studien in noch komplexeren In-vitro-Modellen mit Wirtsgewebe-Komponenten, ex-vivo- Modelle und letztlich randomisierte klinische Studien werden zeigen, wie sich dieses vielversprechende Konzept in die Praxis übersetzen lässt.
Autoren: Jean-Marie Bryl, Dr. Mirko Buchholz und Dr. Nadine Taudte